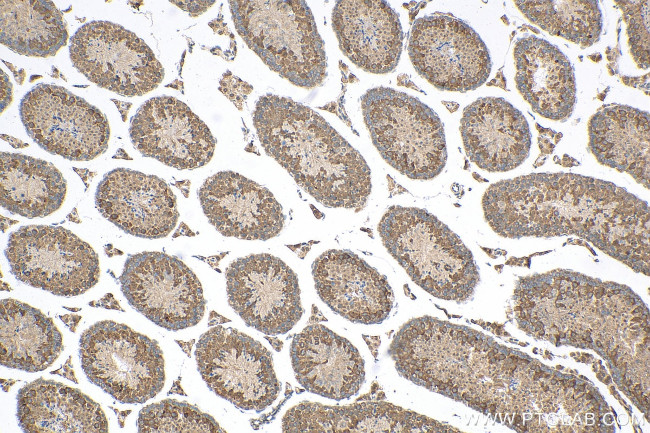
TTC21B Antibody in Immunohistochemistry (Paraffin) (IHC (P))

Search
Proteintech
TTC21B Polyclonal Antibody
{{$productOrderCtrl.translations['antibody.pdp.commerceCard.promotion.promotions']}}
{{$productOrderCtrl.translations['antibody.pdp.commerceCard.promotion.viewpromo']}}
{{$productOrderCtrl.translations['antibody.pdp.commerceCard.promotion.promocode']}}: {{promo.promoCode}} {{promo.promoTitle}} {{promo.promoDescription}}. {{$productOrderCtrl.translations['antibody.pdp.commerceCard.promotion.learnmore']}}
产品信息
30112-1-AP
种属反应
宿主/亚型
分类
类型
抗原
偶联物
形式
纯化类型
保存液
内含物
保存条件
运输条件
产品详细信息
Immunogen sequence: AWLDITRGKE PYTKKALKYF EEGLQDGNDT FALLGKAQCL EMRQNYSGAL ETVNQIIVNF PSFLPAFVKK MKLQLALQDW DQTVETAQRL LLQDSQNVEA LRMQALYYVC REGDIEKAST KLENLGNTLD AMEPQNAQLF YNITLAFSRT CGRSQLILQK IQTLLERAFS LNPQQSEFAT ELGYQMILQG RVKEALKWYK TAMTLDETSV SALVGFIQCQ LIEGQLQDAD QQLEFLNEIQ QSIGKSAELI YLHAVLAMKK NKRQEEVINL LNDVLDTHFS QLEGLPLGIQ YFEKLNPDFL LEIVMEYLSF CPMQ*
靶标信息
The tetratricopeptide repeat (TPR) motif is a degenerate, 34 amino acid sequence found in many proteins and acts to mediate protein-protein interactions in various pathways. At the sequence level, there can be up to 16 tandem TPR repeats, each of which has a helix-turn-helix shape that stacks on other TPR repeats to achieve ligand binding specificity. TTC21B (tetratricopeptide repeat domain 21B), also known as THM1, is a 1,316 amino acid protein that contains 19 TPR repeats and belongs to the TTC21 family. Localizing to cytoplasm and cytoskeleton, TTC21B exists as two alternatively spliced isoforms and is thought to negatively regulate Shh signal transduction. TTC21B may also be involved in retrograde intraflagellar transport in cilia, and is encoded by a gene that maps to human chromosome 2q24.3.
仅用于科研。不用于诊断过程。未经明确授权不得转售。
篇参考文献 (0)
生物信息学
蛋白别名: Intraflagellar transport 139 homolog; Nephronophthisis type12; putative protein product of Nbla10696; Tetratricopeptide repeat protein 21B; tetratricopeptide repeat-containing hedgehog modulator-1; TPR repeat protein 21B; unnamed protein product
基因别名: ATD4; CFAP60; FAP60; FLA17; IFT139; IFT139B; JBTS11; KIAA1992; Nbla10696; NPHP12; SRTD4; THM1; TTC21B
UniProt ID: (Human) Q7Z4L5
Entrez Gene ID: (Human) 79809